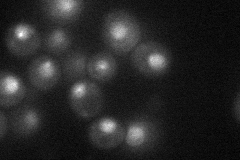

View description
Subunit of chromosomal passenger complex (CPC; Ipl1p-Sli15p-Bir1p-Nbl1p), which regulates chromosome segregation; required for chromosome bi-orientation and for spindle assembly checkpoint activation upon reduced sister kinetochore tension
Localization:
Intensity:
Fold change:
Significance:
-
C’ GFP library in SD

punctate18 -
N' NOP1pr-GFP in SD
nucleus,nucleolus32.5004 -
N' TEF2pr-mCherry in SD

nucleus,nucleolus9.35445 -
N' NATIVEpr-GFP in SD

punctate14.8307 -
N' TEF2pr-VC and Cyto-VN in SD

below threshold25.1643 -
C’ GFP library in SD+DTT

punctate17.790.98No -
C’ GFP library in SD+H2O2

punctate19.271.06No -
C’ GFP library in Starvation Media

punctate17.330.96No -
C’ GFP library on the background of Pup2-DaMP

punctate -
C’ GFP library on the background of CCT mutant

punctate18.59131.03195No
